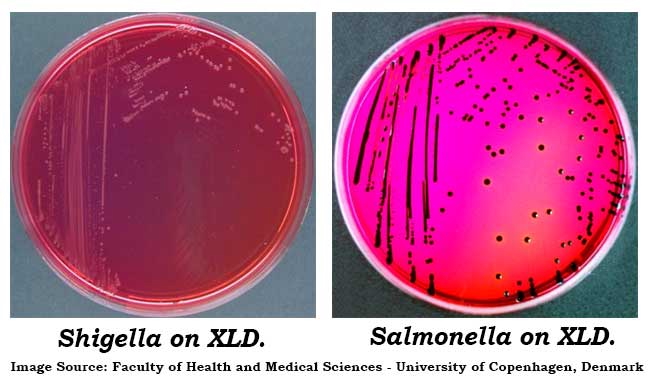

خلاصه محیط کشت XLD
محیط کشت XLD یا محیط مشت Xylose Lysine Deoxycholate Agar یک محیط انتخابی و تمایزی برای جداسازی باکتریهای سالمونلا و شیگلا از نمونههای رودهای است. روش کار آن بر پایه تخمیر زایلوز، دکربوکسیلاسیون لیزین و تولید H2S استوار است که کلنیها را بر اساس رنگ قرمز، زرد یا سیاه تمایز میدهد. این محیط با مهار باکتریهای گرم مثبت توسط دئوکسیکولات، رشد پاتوژنهای هدف را تسهیل میکند و در تشخیص عفونتهای گوارشی کاربرد دارد.
جهت عضویت در کانال آموزشی در تلگرام به لینک زیر مراجعه کنید:
https://t.me/hematology_education
فهرست مطالب محیط کشت XLD
مقدمه محیط کشت XLD
محیط کشت Xylose Lysine Deoxycholate (XLD) Agar یک محیط کشت انتخابی و تمایزی است که برای جداسازی باکتریهای رودهای پاتوژن، به ویژه گونههای سالمونلا (Salmonella) و شیگلا (Shigella)، از نمونههای بالینی، غذایی و محیطی استفاده میشود. این محیط در سال ۱۹۶۱ توسط تیلور توسعه یافت و بر اساس توانایی باکتریها در تخمیر زایلوز (Xylose)، دکربوکسیلاسیون لیزین (Lysine) و عدم تولید هیدروژن سولفید (H2S) در برخی گونهها عمل میکند. ترکیبات اصلی آن شامل زایلوز، لیزین، دئوکسیکولات سدیم (به عنوان مهارکننده باکتریهای گرم مثبت)، فنل رد (به عنوان نشانگر pH)، آگار و سایر مواد مغذی است. دئوکسیکولات باکتریهای گرم مثبت را مهار میکند، در حالی که نشانگرهای تمایزی اجازه میدهند تا کلنیهای مختلف بر اساس رنگ تمایز داده شوند. برای مثال، سالمونلا کلنیهای قرمز با مرکز سیاه تولید میکند، در حالی که شیگلا کلنیهای قرمز بدون سیاه تولید میکند. این محیط به دلیل حساسیت و ویژگی بالا، در آزمایشگاههای میکروبیولوژی بالینی و غذایی بسیار مورد استفاده قرار میگیرد.
کاربرد محیط کشت XLD در جداسازی پاتوژنهای رودهای
XLD Agar عمدتاً برای جداسازی و تمایز پاتوژنهای رودهای مانند سالمونلا و شیگلا از نمونههای مدفوع، غذا، آب و محصولات لبنی استفاده میشود. این محیط در تشخیص عفونتهای گوارشی ناشی از این باکتریها نقش کلیدی دارد و میتواند برای غربالگری نمونههای مشکوک به آلودگی غذایی به کار رود. علاوه بر این، در مطالعات اپیدمیولوژیک برای ردیابی شیوع بیماریهای رودهای مفید است. XLD به ویژه برای جداسازی شیگلا مؤثر است، زیرا اجازه رشد این باکتری را میدهد در حالی که بسیاری از محیطهای دیگر ممکن است آن را مهار کنند. همچنین، میتواند برای تمایز بین سالمونلا (که H2S تولید میکند) و سایر انتروباکتریاسهها مانند اشریشیا کلی (که کلنیهای زرد تولید میکند) استفاده شود. کاربردهای دیگر شامل نظارت بر بهداشت عمومی و کنترل کیفیت در صنایع غذایی است.
روش تهیه محیط کشت XLD
برای تهیه XLD Agar، مراحل زیر را دنبال کنید:
- مواد لازم: حدود ۵۶.۶۸ گرم پودر XLD Agar را در ۱۰۰۰ میلیلیتر آب مقطر یا خالص حل کنید. ترکیبات شامل زایلوز (۳.۵ گرم)، ال-لیزین (۵ گرم)، لاکتوز (۷.۵ گرم)، ساکاروز (۷.۵ گرم)، دئوکسیکولات سدیم (۲.۵ گرم)، کلرید سدیم (۵ گرم)، عصاره مخمر (۳ گرم)، فنل رد (۰.۰۸ گرم)، تیوسولفات سدیم (۶.۸ گرم)، سیترات آمونیوم فریک (۰.۸ گرم) و آگار (۱۳.۵ گرم) است.
- حل کردن: مخلوط را با همزدن مداوم گرم کنید تا به جوش برسد. از حرارت دادن بیش از حد یا اتوکلاو کردن خودداری کنید، زیرا ممکن است محیط را خراب کند.
- ریختن: پس از جوشیدن، محیط را خنک کنید تا حدود ۵۰ درجه سانتیگراد برسد، سپس آن را در پتری دیشهای استریل بریزید.
- ذخیرهسازی: پلیتها را در یخچال (۲-۸ درجه سانتیگراد) نگهداری کنید و قبل از استفاده خشک کنید.
این روش بر اساس استانداردهای ISO 6579-1:2017 است و باید در شرایط استریل انجام شود.
کنترل کیفی محیط کشت XLD
کنترل کیفی محیط کشت XLD برای اطمینان از عملکرد صحیح ضروری است. مراحل شامل:
- بررسی فیزیکی: محیط باید قرمز روشن و شفاف باشد. pH نهایی باید حدود ۷.۴ ± ۰.۲ در ۲۵ درجه سانتیگراد باشد.
- تست رشد: از ارگانیسمهای کنترل استاندارد استفاده کنید:
- سالمونلا تیفی (Salmonella typhimurium): رشد خوب، کلنیهای قرمز با مرکز سیاه (به دلیل تولید H2S).
- شیگلا فلکسنری (Shigella flexneri): رشد خوب، کلنیهای قرمز بدون مرکز سیاه.
- اشریشیا کلی (Escherichia coli): رشد متوسط، کلنیهای زرد (به دلیل تخمیر قندها).
- استافیلوکوکوس اورئوس (Staphylococcus aureus): مهار شده (بدون رشد).
- تست استریلیتی: پلیتها را بدون کشت انکوبه کنید تا از عدم آلودگی اطمینان حاصل شود.
جهت مطالعه جامع در مورد کنترل کیفی میکروب شناسی به لینک زیر مراجعه کنید:
کنترل کیفی میکروب شناسی: اصول، روشها و استانداردهای عملکردی
روش کشت بر روی محیط کشت XLD در آزمایشگاه
روش کشت بر روی XLD Agar به شرح زیر است:
- آمادهسازی نمونه: نمونه (مانند مدفوع یا غذا) را در محیط غنیسازی مانند Selenite Broth کشت دهید تا باکتریهای هدف افزایش یابند.
- کشت مستقیم: با استفاده از لوپ استریل، نمونه را روی سطح پلیت XLD streak کنید (روش چهار بخشی برای جداسازی کلنیها).
- انکوبه کردن: پلیتها را در دمای ۳۵-۳۷ درجه سانتیگراد به مدت ۱۸-۲۴ ساعت (یا تا ۴۸ ساعت برای رشد بهتر شیگلا) انکوبه کنید.
- تفسیر نتایج: کلنیها را بر اساس رنگ بررسی کنید:
- سالمونلا: قرمز با مرکز سیاه.
- شیگلا: قرمز شفاف.
- پروتئوس: قرمز یا زرد با یا بدون مرکز سیاه (اما تمایز با سالمونلا سخت است).
- کلیفرمها: زرد.
هر کلنی مشکوک باید با تستهای بیوشیمیایی تأیید شود.
محیط کشت XLD
محدودیتهای محیط کشت XLD و چالشهای آن
علیرغم مزایا، XLD Agar محدودیتهایی دارد:
- عدم تمایز کامل: برخی سویههای سالمونلا (مانند S. paratyphi A) ممکن است H2S تولید نکنند و کلنیهای مشابه شیگلا ایجاد کنند.
- مهار برخی سویهها: سویههای حساس شیگلا ممکن است رشد ضعیفی داشته باشند.
- نیاز به تأیید: نتایج باید با تستهای سرولوژیکی یا مولکولی تأیید شوند، زیرا تمایز بر اساس ظاهر کلنی ممکن است نادرست باشد.
- عدم انتخابی مطلق: برخی باکتریهای غیرپاتوژن مانند پروتئوس ممکن است رشد کنند و تداخل ایجاد کنند.
- حساسیت به حرارت: تهیه نادرست (مانند حرارت بیش از حد) میتواند عملکرد را کاهش دهد.
سوالات رایج
1. تفاوت XLD با Hektoen Enteric (HE) Agar چیست؟
XLD برای جداسازی شیگلا بهتر است، در حالی که HE برای سالمونلا حساستر است اما ممکن است شیگلا را مهار کند.
2. چرا کلنیهای سالمونلا در محیط XLD سیاه میشوند؟
به دلیل تولید H2S که با آهن واکنش داده و سولفید آهن سیاه ایجاد میکند.
3. آیا XLD برای باکتریهای گرم مثبت مناسب است؟
خیر، دئوکسیکولات آنها را مهار میکند.
4. مدت انقضای پلیتهای آماده XLD چقدر است؟
معمولاً ۲-۴ هفته در یخچال، اما باید کنترل کیفی شود.
5. چگونه کلنیهای زرد در XLD را تفسیر کنیم؟
نشاندهنده تخمیر قندها توسط کلیفرمها مانند E. coli است و معمولاً غیرپاتوژن هستند.
6. pH مناسب برای محیط کشت XLD چیست؟
pH نهایی باید حدود ۷.۴ ± ۰.۲ در ۲۵ درجه سانتیگراد باشد.
7. آیا محیط XLD برای نمونههای غذایی مناسب است؟
بله، برای غربالگری آلودگیهای سالمونلا و شیگلا در مواد غذایی ایدهآل است.
8. نقش زایلوز در XLD چیست؟
زایلوز به عنوان منبع کربن عمل میکند و تخمیر آن توسط باکتریها باعث تغییر رنگ کلنیها میشود.
9. چگونه XLD را استریل کنیم؟
از حرارت دادن تا جوش استفاده کنید، اما اتوکلاو نکنید تا ترکیبات آسیب نبینند.
10. تفاوت کلنی شیگلا و سالمونلا در XLD چیست؟
شیگلا کلنیهای قرمز بدون مرکز سیاه تولید میکند، در حالی که سالمونلا کلنیهای قرمز با مرکز سیاه دارد.
جهت مطالعه بیشتر به لینک زیر مراجعه کنید: